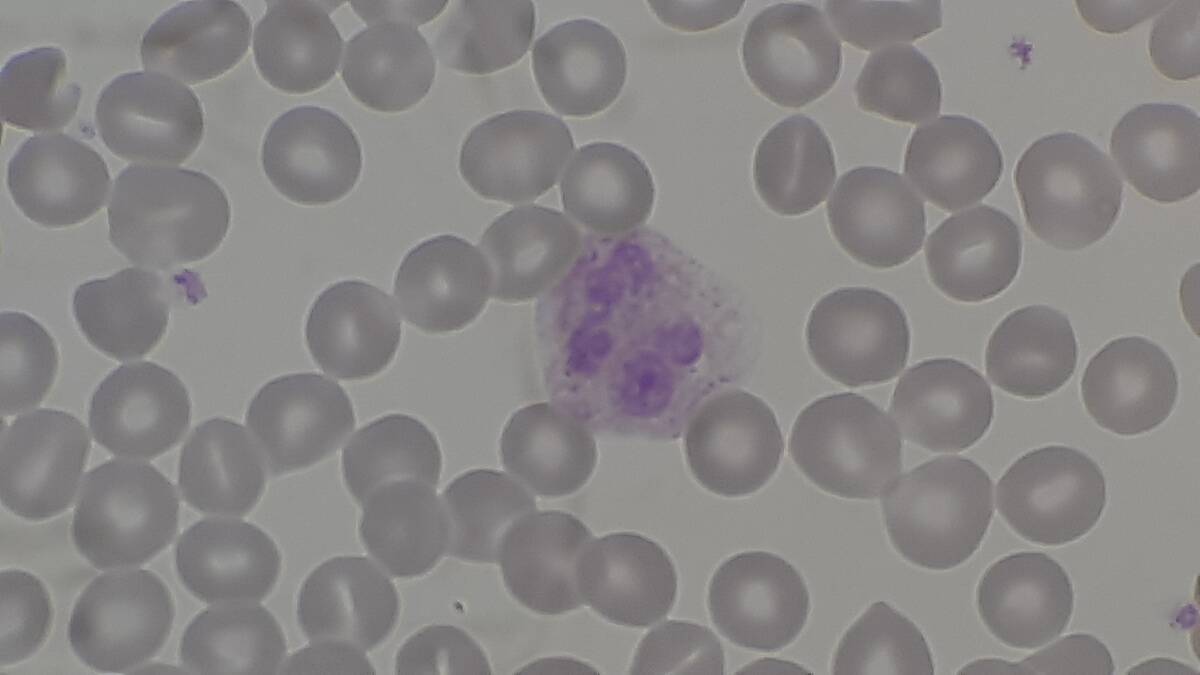
Red_blood_cells_(RBCs),_platelets_and_white_blood_cells_or_leukocyte_(neutrophil)_on_PBS

How toxic particles bypass your immune system unnoticed
Welcome to the mysterious and stealthy realm of toxic particles! These tiny invaders are all around us, often invisible but always on the prowl. From the bustling streets of urban landscapes to the seemingly serene confines of our homes, these particles are experts at infiltration.
Their presence isn’t just a matter of curiosity; understanding them is crucial for our health and well-being.
Understanding Your Immune System’s Defense Mechanisms
Think of your immune system as the body’s personal security team. It tirelessly patrols and defends against foreign invaders, including toxic particles. White blood cells, antibodies, and other defenders work round the clock, identifying and neutralizing threats.
However, even the best security can be bypassed by clever intruders, which is why some particles manage to slip through the cracks.
The Intriguing Journey of Particles Through Your Body

Once particles breach your defenses, they embark on a fascinating journey through your body. Some find their way into the bloodstream, hitching rides to distant organs.
Others might get trapped in tissues, causing inflammation or other issues. The path they take can vary, but the impact is often significant, making it essential to understand how to minimize their travel.
What Are Toxic Particles and Where Do They Come From?

Toxic particles are microscopic solids or liquid droplets suspended in the air. They originate from a variety of sources, including vehicle emissions, industrial processes, and even natural events like wildfires.
Household activities, like cooking and using cleaning products, can also be culprits. Identifying their origins is the first step in tackling their effects on health.
The Art of Disguise: How Particles Camouflage Themselves

Toxic particles are masters of disguise, often cloaking themselves in harmless-looking forms. They can attach to larger, less harmful particles, hitching a ride into the body without raising alarms.
This cunning tactic allows them to bypass initial immune defenses, making detection and removal much harder for our body’s security forces.
The Role of Size: Why Smaller Particles Are More Dangerous

Size matters in the world of toxic particles. The smaller the particle, the easier it is for it to evade defenses and penetrate deep into the body.
Particles less than 2.5 micrometers in diameter, known as PM2.5, are particularly concerning. Their tiny size allows them to reach the deepest parts of the lungs and even enter the bloodstream, posing serious health risks.
Crossing the Barriers: How Particles Penetrate Lung Defenses

The lungs are equipped with a variety of defense mechanisms, including mucus and cilia, to trap and expel particles. However, some toxic particles are adept at slipping past these barriers.
Their small size and physical properties allow them to reach the alveoli, where gas exchange occurs, leading to potential respiratory issues and systemic effects.
The Role of the Skin: A Surprising Gateway for Particles

While the skin is our largest organ and a formidable barrier, it’s not impervious. Some toxic particles are capable of penetrating the skin, especially when it’s damaged or compromised.
This can lead to localized reactions or allow very small particles to enter the bloodstream, highlighting the importance of skin health in defending against environmental toxins.
The Gut’s Vulnerability: How Particles Sneak Past Digestive Defenses

The gut is another potential entry point for toxic particles. Although it has its own set of defenses, including stomach acid and gut flora, particles ingested through food or drink can sometimes slip past.
Once inside, they can disrupt the delicate balance of the gut microbiome or even enter the bloodstream, underscoring the importance of a healthy digestive system.
Air Quality and Its Impact on Particle Infiltration

Air quality plays a crucial role in the prevalence and impact of toxic particles. Poor air quality, often found in urban and industrial areas, increases exposure levels.
Monitoring air quality indices and taking action during high pollution days can significantly reduce the risk of inhaling these harmful particles, making it an important factor in public health strategies.
Everyday Items That Release Toxic Particles

Surprisingly, many everyday items in our homes release toxic particles. Candles, incense, and certain cleaning products can all contribute to indoor air pollution. Even activities like cooking can generate particles. Being aware of these sources and choosing less harmful alternatives can help reduce the presence of toxic particles in our living spaces.
How Urban Environments Increase Particle Exposure

Urban environments, with their dense traffic and industrial activities, are hotspots for toxic particle exposure. The concentration of vehicles and factories leads to higher levels of pollutants in the air.
This makes city dwellers more susceptible to the health impacts of these particles, highlighting the need for urban planning and policies that prioritize air quality.
The Role of Genetics in Immune System Response

Genetics can influence how our immune system responds to toxic particles. Some people may have genetic variations that make them more resilient, while others might be more susceptible to the effects of these invaders.
Understanding these genetic factors can lead to more personalized strategies for prevention and treatment, tailoring approaches to better protect at-risk individuals.
The Impact of Stress and Lifestyle on Immune Efficacy

Stress and lifestyle choices can significantly impact immune system efficacy. Chronic stress, poor diet, and lack of exercise weaken the body’s defenses, making it easier for toxic particles to wreak havoc.
Incorporating stress-reduction techniques, a balanced diet, and regular physical activity can bolster the immune system, providing better protection against environmental threats.
The Future of Research: Detecting and Defending Against Toxic Particles

Research is continually evolving, aiming to detect and defend against toxic particles more effectively. Advances in technology, such as improved air quality monitoring and new filtration systems, offer hope for reducing exposure.
Ongoing studies into how particles interact with the body will help develop better strategies for prevention and treatment, making the future look promising.